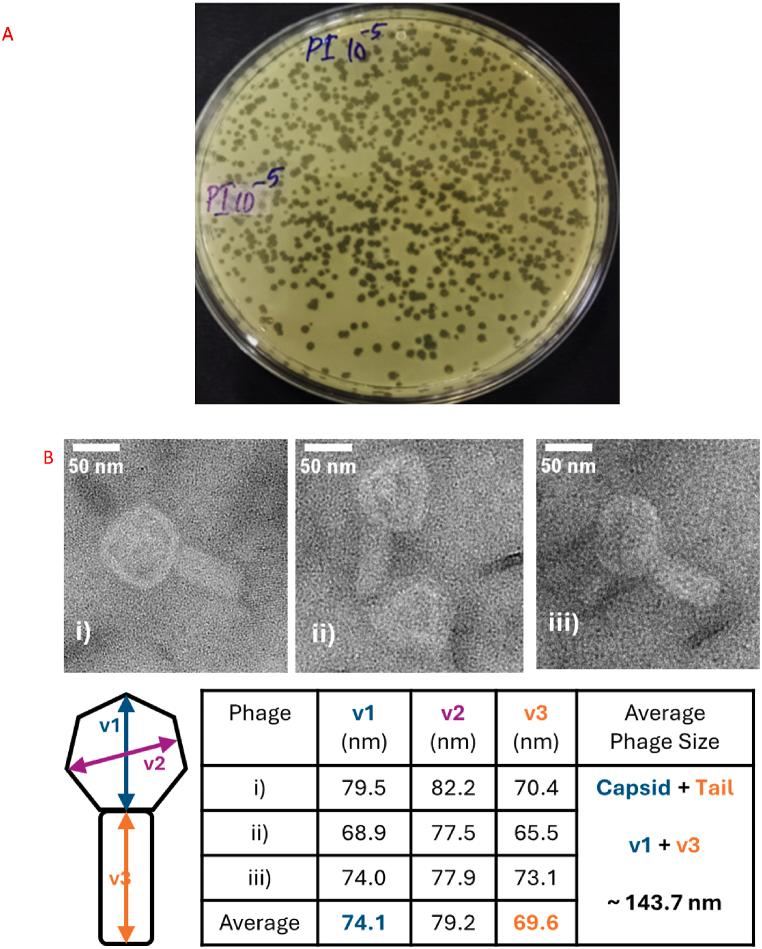

野生型和噬菌体抗性产黑变菌素菌株的相对适合度以及联合治疗对抗性形成的影响。
Relative fitness of wild-type and phage-resistant pyomelanogenic and effects of combinatorial therapy on resistant formation.
作者信息
Mary Aarcha Shanmugha, Kalangadan Nashath, Prakash John, Sundaresan Srivignesh, Govindarajan Sutharsan, Rajaram Kaushik
机构信息
Department of Microbiology, Central University of Tamil Nadu, Thiruvarur, Tamil Nadu, India.
Department of Chemistry, Central University of Tamil Nadu, Thiruvarur, Tamil Nadu, India.
出版信息
Heliyon. 2024 Nov 2;10(21):e40076. doi: 10.1016/j.heliyon.2024.e40076. eCollection 2024 Nov 15.
Bacteriophages, the natural predators of bacteria, are incredibly potent candidates to counteract antimicrobial resistance (AMR). However, the rapid development of phage-resistant mutants challenges the potential of phage therapy. Understanding the mechanisms of bacterial adaptations to phage predation is crucial for phage-based prognostic applications. Phage cocktails and combinatorial therapy, using optimized dosage patterns of antibiotics, can negate the development of phage-resistant mutations and prolong therapeutic efficacy. In this study, we describe the characterization of a novel bacteriophage and the physiology of phage-resistant mutant developed during infection. M12PA is a -infecting bacteriophage with Myoviridae morphology. We observed that prolonged exposure of to M12PA resulted in the selection of phage-resistant mutants. Among the resistant mutants, pyomelanin-producing mutants, named PA-M, were developed at a frequency of 1 in 16. Compared to the wild-type, we show that PA-M mutant is severely defective in virulence properties, with altered motility, biofilm formation, growth rate, and antibiotic resistance profile. The PA-M mutant exhibited reduced pathogenesis in an allantoic-infected chick embryo model system compared to the wild-type. Finally, we provide evidence that combinatory therapy, combining M12PA with antibiotics or other phages, significantly delayed the emergence of resistant mutants. In conclusion, our study highlights the potential of combinatory phage therapy to delay the development of phage-resistant mutants and enhance the efficacy of phage-based treatments against .
噬菌体作为细菌的天然捕食者,是对抗抗菌耐药性(AMR)的极具潜力的候选者。然而,噬菌体抗性突变体的快速出现对噬菌体疗法的潜力构成了挑战。了解细菌适应噬菌体捕食的机制对于基于噬菌体的预后应用至关重要。噬菌体鸡尾酒疗法和联合疗法,采用优化的抗生素给药模式,可以抑制噬菌体抗性突变的产生并延长治疗效果。在本研究中,我们描述了一种新型噬菌体的特征以及感染过程中产生的噬菌体抗性突变体的生理学特性。M12PA是一种感染 的噬菌体,具有肌尾噬菌体科的形态。我们观察到, 长时间暴露于M12PA会导致噬菌体抗性突变体的产生。在抗性突变体中,产生焦黑素的突变体,命名为PA-M,出现频率为十六分之一。与野生型相比,我们发现PA-M突变体在毒力特性方面存在严重缺陷,其运动性、生物膜形成、生长速率和抗生素抗性谱均发生了改变。与野生型相比,PA-M突变体在尿囊感染的鸡胚模型系统中表现出致病性降低。最后,我们提供证据表明,将M12PA与抗生素或其他噬菌体联合使用的联合疗法显著延迟了抗性突变体的出现。总之,我们的研究突出了联合噬菌体疗法在延迟噬菌体抗性突变体产生以及提高基于噬菌体的 治疗效果方面的潜力。